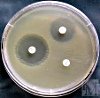

Другие названия и синонимы
Sowing for flora with an antibioticogram in women.
Описание
Бактериологическую культуру флоры с антибиотиком в гинекологии используют для определения неспецифической микрофлоры в материале, взятом из половых путей, выявления потенциального возбудителя воспалительного процесса и определения его чувствительности к антибактериальным препаратам. Антибиограмма - это список антибиотиков, для которых существует чувствительность или нечувствительность отдельных культур микроорганизмов. Бактериологический посев исследуемого материала проводится на специальных питательных средах, помещенных в благоприятные условия для размножения микроорганизмов.
Бактериологическую культуру флоры с антибиотиком в гинекологии используют для определения неспецифической микрофлоры в материале, взятом из половых путей, выявления потенциального возбудителя воспалительного процесса и определения его чувствительности к антибактериальным препаратам. Антибиограмма - это список антибиотиков, для которых существует чувствительность или нечувствительность отдельных культур микроорганизмов.
Бактериологическую культуру флоры с антибиотиком в гинекологии используют для определения неспецифической микрофлоры в материале, взятом из половых путей, выявления потенциального возбудителя воспалительного процесса и определения его чувствительности к антибактериальным препаратам. Антибиограмма - это список антибиотиков, для которых существует чувствительность или нечувствительность отдельных культур микроорганизмов.
|
|
Дополнительные факты
Бактериологический (культуральный) посев испытуемого материала проводят на специальных питательных субстратах, помещенных в благоприятные условия для размножения микроорганизмов, с последующей оценкой результатов (выявление микроорганизмов и проверка их биохимических и биологических свойств). Специальные тесты для определения восприимчивости к антибиотикам, антисептики и бактериофагов позволяют пациенту моделировать воздействие химиотерапевтических препаратов на изолированные микроорганизмы и выбирать эффективный препарат в конкретном случае.
Бактериологический посев на флору обладает высокой специфичностью, но имеет свои недостатки: длительный период исследований; повышенные требования к сбору; высокая квалификация лабораторного персонала и, следовательно, продление срока лечения. Клиническая гинекология применяет бактериологический посев во флору в качестве дополнения к другим лабораторным исследованиям (микроскопия мазка с использованием окрашивания по Граму, ИФА и ПЦР).
Материал, взятый у пациента, высевается на специальные питательные среды (чаще - выборочные и дифференциально-диагностические среды, обеспечивающие преимущественный рост определенных видов микроорганизмов). Питательная среда с биоматериалом помещается в термостаты, поддерживающие благоприятные условия для размножения микроорганизмов (температура, влажность). Через определенное время проводится контрольная экспертиза роста микроорганизмов на питательных средах. В то же время оцениваются видимые характеристики микробных колоний (их размер, плотность, цвет, форма). При необходимости проводят исследование материала под микроскопом. Чтобы дифференцировать сходные микроорганизмы, проводится дополнительное исследование с использованием биохимического ряда.
В результате бактериологического посева на флору чистые культуры (штаммы) микроорганизмов выделяются, идентифицируются и количественно определяются в единицах КОЕ (единица образования колоний). Существует 4 степени роста условно-патогенных микроорганизмов во время первичного сева: I и II степени (очень слабый и плохой рост) - большую часть времени мы говорим о внешнем загрязнении, III (умеренный) и IV (обильный) уровни роста - о причинной роли этого микроорганизма в развитии воспаления.
Важным преимуществом бактериологического посева на флору является определение чувствительности этого микроорганизма к антибиотикам. Составление антибиотикограмм обеспечивает подбор оптимального препарата для лечения, что важно в условиях распространенных антибиотикорезистентных штаммов микроорганизмов. Для этой цели используется метод бумажного диска или метод серийного разбавления. Ведущим методом является дисковый диффузионный метод, в котором эффективность антибактериальных препаратов определяется диаметром зоны ингибирования роста микроорганизма вокруг дисков, пропитанных различными концентрациями антибиотиков. Наиболее точный в количественном отношении, но более кропотливый - метод серийных (последовательных) разведений антибиотиков в жидких и плотных питательных средах.
Результаты антибиограммы выражены в единицах MIC (минимальная ингибирующая концентрация). Для достижения терапевтического эффекта важно, чтобы концентрация препарата в крови пациента была примерно в 4-8 раз выше, чем МИК.
Бактериологический посев на флору обладает высокой специфичностью, но имеет свои недостатки: длительный период исследований; повышенные требования к сбору; высокая квалификация лабораторного персонала и, следовательно, продление срока лечения. Клиническая гинекология применяет бактериологический посев во флору в качестве дополнения к другим лабораторным исследованиям (микроскопия мазка с использованием окрашивания по Граму, ИФА и ПЦР).
Забор материала.
Биологический материал отбирается гинекологом во время исследования влагалищного зеркала в соответствии с правилами асептики. Как правило, материал, необходимый для бактериологического посева на флору, поступает из цервикального канала, заднего свода влагалища и мочеиспускательного канала. Перед взятием мазка Папаниколау необходимо удалить слизистую пробку и обработать шейку матки стерильным физиологическим раствором. Образцы биоматериала отбирают стерильным ватным тампоном, помещают в стерильный контейнер, маркируют и незамедлительно отправляют в бактериологическую лабораторию. Тампон при извлечении не должен касаться стенок влагалища. Когда практикуется бартолинит, перфорируйте бартолиновые железы. Содержимое абсцессов удаляется стерильным ватным тампоном. Материал для исследования из матки берется с помощью специального инструмента, такого как шприц-аспиратор. В случае воспаления матки материал удаляется из источника инфекции либо во время операции, либо с помощью диагностического укуса в полостях влагалища.Бактериологическое исследование.
Основными этапами исследования являются: высев биоматериала на питательные среды; выделение чистых культур (штаммов) микроорганизмов; идентификация и дифференциация изолированных микробных культур; тесты in vitro на чувствительность микроорганизмов к антибиотикам, антисептикам и бактериофагам.Материал, взятый у пациента, высевается на специальные питательные среды (чаще - выборочные и дифференциально-диагностические среды, обеспечивающие преимущественный рост определенных видов микроорганизмов). Питательная среда с биоматериалом помещается в термостаты, поддерживающие благоприятные условия для размножения микроорганизмов (температура, влажность). Через определенное время проводится контрольная экспертиза роста микроорганизмов на питательных средах. В то же время оцениваются видимые характеристики микробных колоний (их размер, плотность, цвет, форма). При необходимости проводят исследование материала под микроскопом. Чтобы дифференцировать сходные микроорганизмы, проводится дополнительное исследование с использованием биохимического ряда.
В результате бактериологического посева на флору чистые культуры (штаммы) микроорганизмов выделяются, идентифицируются и количественно определяются в единицах КОЕ (единица образования колоний). Существует 4 степени роста условно-патогенных микроорганизмов во время первичного сева: I и II степени (очень слабый и плохой рост) - большую часть времени мы говорим о внешнем загрязнении, III (умеренный) и IV (обильный) уровни роста - о причинной роли этого микроорганизма в развитии воспаления.
Важным преимуществом бактериологического посева на флору является определение чувствительности этого микроорганизма к антибиотикам. Составление антибиотикограмм обеспечивает подбор оптимального препарата для лечения, что важно в условиях распространенных антибиотикорезистентных штаммов микроорганизмов. Для этой цели используется метод бумажного диска или метод серийного разбавления. Ведущим методом является дисковый диффузионный метод, в котором эффективность антибактериальных препаратов определяется диаметром зоны ингибирования роста микроорганизма вокруг дисков, пропитанных различными концентрациями антибиотиков. Наиболее точный в количественном отношении, но более кропотливый - метод серийных (последовательных) разведений антибиотиков в жидких и плотных питательных средах.
Результаты антибиограммы выражены в единицах MIC (минимальная ингибирующая концентрация). Для достижения терапевтического эффекта важно, чтобы концентрация препарата в крови пациента была примерно в 4-8 раз выше, чем МИК.
